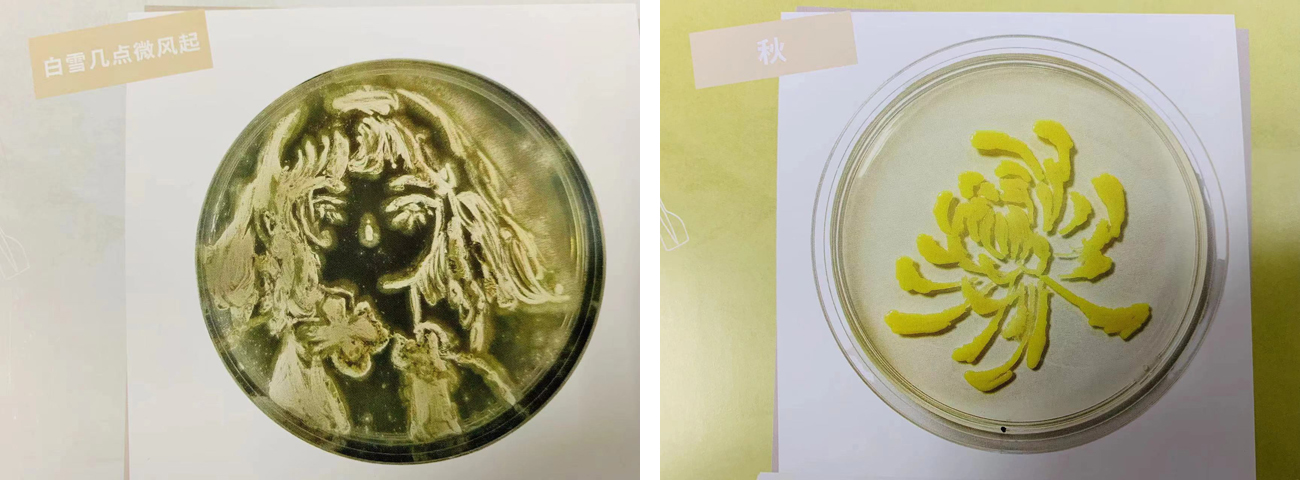

近期,由华东五校(上海交通大学、复旦大学、太阳成集团tyc33455cc、浙江大学、中国科学技术大学)国家级生物学实验教学示范中心联盟举办的“首届微生物艺术画竞赛”落下帷幕,国家级实验教学示范中心(太阳成集团tyc33455cc)代表队表现出色,共获得一等奖作品4个(顾烁天团队、唐天爽团队)、二等奖作品2个(唐天爽团队)、三等奖作品9个(顾烁天、丽彤团队、唐天爽、陈孙熠、苗逸帆团队)。
微生物艺术画是指以微生物实验中常用的琼脂平板为图纸,利用微生物生长形成的图案作画。将科学、人文与艺术相结合,帮助员工发现科学的乐趣,提升科学素养,培养创新思维及创造力,提升团队协作和动手实验能力,挖掘发现问题、解决问题的潜能。
华东五校国家级生物学实验教学示范中心联盟为推动微生物实验教学,活跃员工科研生活气氛,举办了微生物艺术画大赛。公司21级本科生依托国家级实验教学示范中心的微生物实验教学课程,在张博、邵珠卿、史净三位任课教师和示范中心高倩倩老师的指导下积极参加活动,共26名同学提交了15副作品图参赛。




在本次活动中,示范中心与同学们一起克服了时间紧,菌种要求高等各种困难,以示范中心提供的菌种为基础,展开科学、艺术的结合,同学们运用微生物学中细菌和真菌的生长特性、外部形态结构差异性以及菌落色彩的差异性,发挥自己的想象,采用勾描、涂布等手段,勾勒出一幅幅精美的画作。经过多次尝试,在培养皿的方寸之间,描绘了惟妙惟肖的各种景物,展现了微生物实验的多姿多彩和独特魅力。通过本次比赛,促进了员工进一步掌握了金黄色葡萄球菌、枯草芽孢杆菌、酿酒酵母等十余种微生物的典型形态和生长特性。取得了科学性和艺术性相结合的良好示范教学效果。
实验教学示范中心联盟诚邀生命科学专业的员工积极参与到此类活动中,通过各种举措充分体现其引领作用,以“大生命科学”人才培养为目标,进一步实现华东地区生物科学类教学资源的开放共享,培养更多的创新人才。
获奖作品展示:
【一等奖作品】

【二等奖作品】

文字:高倩倩
审核:张骑鹏、朱景宁